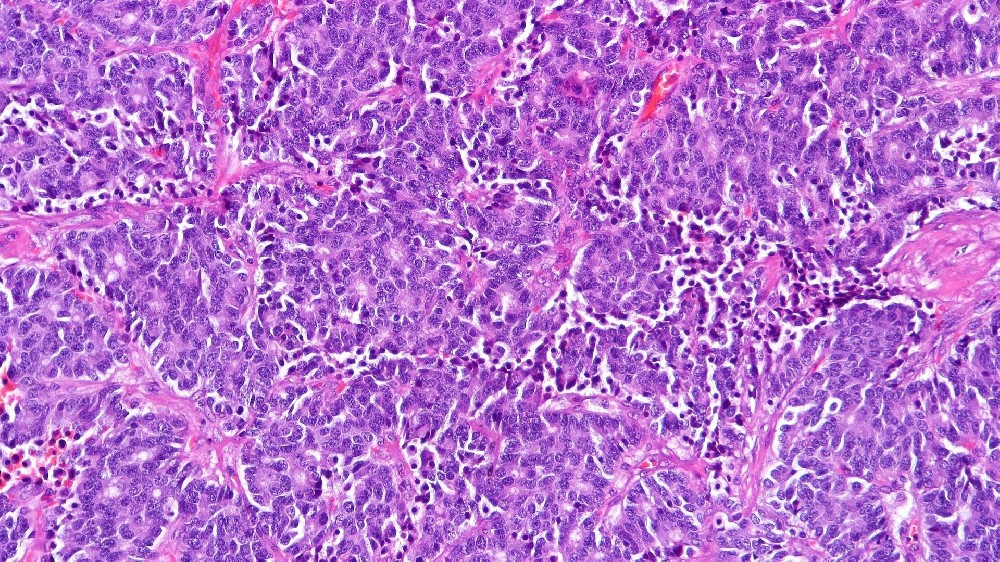
類癌（神經內分泌腫瘤）

什麼是類癌(神經內分泌腫瘤)?
類癌(神經內分泌腫瘤) 是指由神經內分泌細胞(能夠向血液中釋放荷爾蒙的特殊細胞結構)產生的一種獨特癌症。這些腫瘤主要發生在胃腸道、肺部、胰臟和肝臟的不同部位。
瞭解類癌腫瘤 (神經內分泌腫瘤) 是非常重要的,因為它的表現與許多其他癌症不同。與一般快速成長的惡性腫瘤不同,類癌通常會呈現較緩慢的進展,提供了相當多的治療干預機會。然而,由於荷爾蒙分泌和相關症狀,這些腫瘤帶來了一系列的挑戰。
生物基礎與癌細胞新陳代謝
神經內分泌細胞專門合成血清素、胰島素、胰高血糖素和胃泌素等神經激素。類癌(神經內分泌腫瘤)的發展與這些細胞類型的障礙有密不可分的關係,其特點是不受控制的細胞增生和荷爾蒙過度分泌。
癌細胞的新陳代謝模式是最基本的特徵,尤其是沃伯格效應 (Warburg Effect),這是諾貝爾獎得主奧托‧沃伯格 (Otto Warburg) 首次描述的現象。癌細胞(包括類癌細胞)的新陳代謝傾向於糖酵解,消耗葡萄糖的速度比正常細胞高約 200 倍,即使在富氧的條件下也是如此。這種新陳代謝的弱點提供了獨特的針對性治療方法,突顯了創新的新陳代謝腫瘤學策略,例如李國華博士和劉國龍教授等知名專家所開創的策略。
類癌(神經內分泌腫瘤)的發病率
在全球範圍內,類癌(神經內分泌腫瘤)呈上升趨勢,約佔新診斷癌症病例的 2%。在香港及其他亞洲地區,由於診斷技術的改進及醫護人員對此類腫瘤的認知提高,此類腫瘤已逐漸被認可。
在包括香港在內的亞洲國家,胃腸神經內分泌腫瘤是最主要的亞型。值得注意的是,香港每年每 10 萬人中約有 5-10 個新病例。發現率的增加反映了內視鏡方法和影像技術的進步,強調早期診斷和改善治療效果。
亞洲的受影響人口和風險概況
類癌(神經內分泌腫瘤)常見於 50 至 70 歲的成年人。雖然這些腫瘤可能發生在任何性別,但在亞洲群組的觀察研究中,發現女性略佔優勢。
由於累積的風險因素增加,老齡人口的發病率較高。
由於各地區在醫療照護方面的差異,以及早期篩檢的有限性,亞洲國家在初次就診時肝轉移腫瘤的發生率特別高。
在亞洲人口中,可能與乙型肝炎等慢性感染有關,尤其是肝局部的腫瘤。
類癌(神經內分泌腫瘤)的身心影響
類癌(神經內分泌腫瘤)患者可能會經歷多種症狀,從持續性腹部不適、潮紅、腹瀉和疲勞,到因不確定病情而產生的嚴重情緒困擾。
嚴重疲勞,影響日常活動和生活品質。
持續性疼痛,通常是因為腫瘤對周圍器官和組織造成負擔壓力。
心理負擔,由長期性和荷爾蒙波動引發的情緒或焦慮障礙所造成。
all cancers的創新療法以諾貝爾獎得主認可的新陳代謝研究和獨家 4D 治療為後盾,旨在減輕這些影響,改變病患的體驗,讓他們擁有更高的功能和更好的生活品質。
類癌(神經內分泌腫瘤)的成因和風險因素
遺傳和分子風險因素
多種遺傳和分子機制促成類癌(神經內分泌腫瘤)的發病和發展,包括散發和遺傳傾向:
MEN1 (Multiple Endocrine Neoplasia type 1,多發性內分泌瘤病) 等基因突變常與較高的發病率有關,影響遺傳傾向。
Rb、TP53 和 mTOR 通路的改變會導致類癌細胞出現不受控制的細胞生長。
最近的研究也突顯了管理葡萄糖代謝的代謝失調基因,突顯了針對性代謝治療的潛力。
環境和生活方式因素
雖然類癌腫(神經內分泌腫瘤)的特定致病生活方式因素不如某些其他惡性腫瘤明確,但幾種環境關係仍與臨床相關:
長期吸煙與肺類癌,特別是在肺類癌亞群中出現的病例。
長期暴露於某些化學物質和輻射,在有限的國際研究中有所記錄。
與肥胖、新陳代謝綜合症和慢性發炎狀態有關,這在新興亞洲群體中得到證明。
代謝脆弱性:關鍵治療目標
類癌腫瘤顯著依賴異常的葡萄糖代謝(沃伯格效應)和谷氨酰胺來進行核苷酸合成和細胞增殖:
類癌腫瘤細胞中約有 50% 嚴重依賴穀胺,這對於透過新的代謝干預來瞄準目標非常重要。
類癌細胞的糖酵解率提供了易受傷害的部位,可以治療性地利用新陳代謝抑制劑,例如all cancers所開發的新陳代謝抑制劑。
地區特定因素:香港及亞洲背景
香港人口老化帶來更大的風險,而當地的情況更進一步擴大了這種易受影響的程度:
在亞洲人口中,乙型肝炎病毒感染與致癌和致突變風險有關的發病率增加。
飲食因素包括醃製和發酵食物的攝取,會顯著增加亞洲地區特有的胃腸類癌腫瘤。
鼓勵根據當地流行病學發現進行早期篩檢,對於預防策略而言至關重要。
透過專注於早期偵測篩檢,並利用新陳代謝脆弱性開發的突破性技術,診斷出類癌 (神經內分泌腫瘤) 的病患可以得到有效的管理,提高存活率、疾病慢性化程度,並改善生活品質,以達成all cancers2025 年的宏大目標,將具挑戰性的癌症轉變為可管理的慢性疾病。
類癌(神經內分泌腫瘤)的症狀
認識類癌腫瘤(神經內分泌腫瘤)的早期症狀可以大大提高預後和治療的成功率。症狀常因腫瘤的部位和是否產生荷爾蒙而異,因而有不同的表現。儘管最初的症狀可能很微弱或沒有特異性,但若能及早發現,將可大幅改善病患的預後。
類癌(神經內分泌腫瘤)的一般症狀:
持續疲勞
不明原因的體重下降
腹部不適或腹脹
排便模式改變,例如腹瀉或便秘
皮膚潮紅或發紅
噁心或嘔吐
食慾不振
如果肺部受累,則會持續或反覆咳嗽
如果支氣管樹受到影響,則會出現呼吸困難或喘鳴。
心悸或心跳加速,如果荷爾蒙釋放會影響心臟功能
類癌綜合症特有的症狀(腫瘤釋放荷爾蒙時):
皮膚潮紅,特別是臉部和頸部,由壓力或某些食物引發
慢性水瀉
腹痛和絞痛
心悸、心動過速
呼吸困難、支氣管痙攣
右側心臟瓣膜受累,導致心臟雜音
特定階段的症狀和疾病進展:
類癌(神經內分泌腫瘤)的症狀會隨著病情發展而變化。在症狀出現時立即就醫,及早發現是提高存活率的基石。
早期階段: 腫瘤通常無症狀或症狀輕微、無特異性,很容易被忽略,這強調了例行健康篩檢對高風險族群的價值。
中級階段: 症狀可能比較明顯,包括持續的腹部不適、不明原因的體重下降和間歇性腹瀉。
後期(晚期): 由全身性荷爾蒙釋放引起的嚴重荷爾蒙症狀,如劇烈的皮膚潮紅、長期腹瀉和顯著的心血管併發症,以及因轉移引起的身體症狀(如骨痛)。
由於類癌的位置和行為各不相同,因此在發現持續症狀時,及時的醫療評估和干預對達到最佳預後起著關鍵作用。
類癌(神經內分泌腫瘤)的分期和存活率
類癌(神經內分泌腫瘤)的準確分期對於引導最佳治療決策至關重要。存活率和治療方案會根據診斷出的腫瘤分期而有顯著的差異,並受到腫瘤部位、大小、擴散程度和荷爾蒙分泌能力的影響。
第 1 期 - 類癌(神經內分泌腫瘤)
在這個最早的階段,腫瘤通常是局部性的,而且體積很小,直徑通常低於兩公分。重點包括
常見無症狀或輕微、非特異性症狀
腫瘤僅限於原來的位置(如胃腸道、肺部)
手術切除通常是根治性的,輔助治療的必要性極低
存活率: 由於及早發現和有效的手術介入,局部神經內分泌腫瘤的五年存活率超過 90%(香港腫瘤科統計資料,2024)。
第 2 期 - 類癌(神經內分泌腫瘤)
在此階段,腫瘤會擴大或呈現微妙的擴散至鄰近組織或局部淋巴結:
輕微症狀,包括局部疼痛或偶爾腸胃不適
手術複雜性增加,通常輔以局部放射治療,以確保徹底切除腫瘤
可以開始使用體司他丁類似物來控制症狀
存活率: 約 75-85% 的五年存活率,顯示出亞洲主要醫療中心在及時的多學科介入下,預後良好。
第 3 期 - 類癌(神經內分泌腫瘤)
此晚期階段會出現明顯的區域擴散,通常會累及許多淋巴結和周圍組織或結構:
顯著的症狀,例如持續性疼痛、排便習慣改變、荷爾蒙過量引起的慢性腹瀉、呼吸道併發症(肺類癌)
需要多層面的管理,包括手術切除、先進的放射治療、系統性標靶治療
強烈建議進行荷爾蒙症狀管理的全身性干預 (例如:長效體脂素類似物)
存活率: 範圍從 50% 到高達 70%,主要取決於持續的醫院監測、早期干預,以及 2024 年香港癌症綜合登記中記錄的激素產生變異的支持性護理。
第 4 期 - 類癌(神經內分泌腫瘤)
在這個階段,腫瘤已經轉移,影響到遠端的器官,主要是肝臟、肺、骨頭或腦部:
嚴重的全身症狀和荷爾蒙分泌增加,會對患者的生活品質造成重大影響。
需要系統性治療,例如針對性分子療法 (例如肽受體放射治療 - PRRT)、生物療法、免疫療法,以及利用 Warburg 和谷氨酰胺代謝漏洞的新型代謝療法
症狀處理包括針對荷爾蒙併發症、疼痛處理、營養照護和社會心理支援的支援性療法。
存活率: 近年來有顯著的改善,目前亞太地區的登錄報告顯示,使用創新療法的 3 年存活率可達 30-45%。強調類癌轉型為慢性可管理病症的目標,與「all cancers」2025 年的慢性病管理模式願景一致。
有效应对晚期疾病的重点是有效控制症状,显著延长生存时间并提高生活质量。令人鼓舞的是,來自知名機構的尖端創新和全球合作研究,即使是在轉移期,也有助於改善結果和延長生產壽命。
類癌(神經內分泌腫瘤)傳統療法的局限性
儘管腫瘤學發展迅速,但類癌腫瘤(神經內分泌腫瘤)的傳統治療方法仍存在許多限制,嚴重影響患者的療效。化療、放射治療和手術等治療方法雖然在許多病例中有益,但往往會產生嚴重的副作用,而且在疾病晚期的療效有限。
化療及其相關毒性
化學治療仍是類癌(神經內分泌腫瘤)的常見治療選擇,然而其療效往往被高發的不良反應所抵消,大大降低了患者的生活品質。根據香港腫瘤中心最近的資料顯示,約有 78% 在化療後出現嚴重骨髓抑制,導致更容易感染、貧血和血小板缺乏,往往需要進一步的醫療干預。
骨髓抑制風險: ~78%
心臟毒性風險:~23%
需要住院的感染風險增加
二次癌症風險增加約 300% (JAMA Oncology, 2023)
近四分之一 (23%) 的患者會受到心臟毒性的影響,進一步加重醫療併發症,通常會導致心臟功能減退和潛在的慢性心臟病。化療後繼發惡性腫瘤的累積風險進一步加重了患者的擔憂,使得化療對香港及亞洲地區的年輕患者尤為危險。
放射治療與長期組織損傷
放射治療是利用高能量輻射來消除癌細胞,但針對類癌腫瘤(神經內分泌腫瘤)的應用一般仍較缺乏針對性。因此,腫瘤部位附近的健康組織經常受到損害,導致嚴重的長期併發症,如腸胃毒性、持續性發炎、疤痕(纖維化),甚至細胞突變,使患者容易罹患繼發性癌症。
亞太癌症研究所(2024)的資料顯示,主要由於輻射引起的附帶損害,包括:患者相當不滿:
組織壞死和軟組織纖維化
腸胃受損(導致長期腹瀉、腹痛)
治療後繼發惡性增生的風險升高約 80-120%
治療後出現嚴重疲勞和生活方式紊亂
手術介入:風險與限制
手術仍是治療類癌(神經內分泌腫瘤)的基石,主要適用於早期病患。然而,手術替代方案在晚期階段經常面臨挑戰,包括手術複雜性增加,以及因廣泛轉移擴散而限制病患的治療資格。
根據香港癌症資料統計中心(2024)的臨床報告,外科介入手術,尤其是複雜的手術,如肝切除術或腸切除術,具有重大的手術風險,例如:
術後感染影響 12-20% 的病患
失血過多,可能需要輸血
延遲傷口癒合和慢性切口不適
大規模手術後功能不佳,日常生活受到影響
對晚期和轉移性疾病的療效有限
不幸的是,傳統療法在晚期階段的療效仍低得驚人。在轉移性類癌病例中,客觀反應率 (ORR) 通常低於約 21%,突顯了一個重要的治療缺口,使大量患者面臨風險,尤其是亞洲人口已在與流行的地區性癌症類型作鬥爭。
長期的臨床評估顯示,癌症的新陳代謝適應力是治療效果有限的重要原因。神經內分泌腫瘤中的癌細胞持續展現新陳代謝的適應性,不僅呈現侵略性的沃伯格效應 (Warburg effect),消耗葡萄糖的速度幾乎是正常細胞的 200 倍,而且還利用其他新陳代謝途徑,例如谷氨酰胺新陳代謝、脂肪酸氧化和自噬途徑,有效地繞過了傳統的治療目標。
代謝抵抗機制
傳統治療類癌(神經內分泌腫瘤)的一個關鍵障礙涉及代謝抵抗機制。最近的 Nature Medicine 研究 (2024) 強調了癌症神經內分泌細胞間 DNA 修復活性增強的重要作用,顯示與正常細胞相比,DNA 修復酵素的表達量增加了高達 400%。這種新陳代謝適應性大大有助於抵抗 DNA 損傷療法,如化療和放射治療。
DNA 修復能力增強 (~400% 高於正常細胞)
葡萄糖消耗率增加約 200 倍的沃伯格效應
谷氨酰胺依賴性和代謝可塑性會增加抵抗力
針對標準細胞凋亡通路的療法成效有限
因此,由於神經內分泌腫瘤所展現的這些複雜生存機制,傳統治療方法的療效仍會大打折扣。
結論:創新治療的迫切需要
考慮到上述限制因素,針對類癌腫瘤(神經內分泌腫瘤)的新穎療法存在著巨大的需求,以解決其代謝復原能力和傳統治療的差距。新陳代謝靶向療法和個性化醫學平台等突破性治療方法,目前正由香港深圳前海泰康等領先機構與包括 MD Anderson 在內的國際機構合作率先推出,為減輕這些限制提供了新的途徑。
由諾貝爾獎得主李國華博士和劉國龍教授等著名專家指導研發,4D 治療等新型癌症治療方法旨在大幅改善患者的療效,提高生活品質,最終實現在 2025 年前慢性控制類癌(神經內分泌腫瘤)的目標。
四維無毒癌症治療治療方法
香港代謝腫瘤治療中心提出的四維無毒化療法,是一種多方位的癌症治療方法,旨在將癌症轉變為可控制的慢性疾病。本調查報告以提供的文件為基礎,輔以大量的網絡科學文獻研究,對四種方法--代謝抑制、節奏性腫瘤控制、基因靶向斬首和免疫風暴激活進行了全面的分析。分析內容包括科學原理、臨床證據和潛在挑戰,並提出口號和標語。
代謝抑制
摘要與機制:此方法針對癌細胞新陳代謝的弱點,特別是它們對葡萄糖、穀胺和脂質合成的依賴。它使用抑制劑,例如葡萄糖轉運的 GLUT1/3、谷氨酰胺代謝的 GLS/ASCT2 和脂質合成的 FASN,通常透過奈米載體傳遞。AI 驅動的營養調節可提高精確度,目的是誘發 ATP 危機並削弱癌細胞。文件聲稱 82% 可減少腫瘤的葡萄糖攝取,79% 可減少血漿穀胺,91% 可減少膜磷脂合成。
科學基礎:研究,例如 在精確腫瘤學時代,以癌症代謝為目標研究證實癌細胞的新陳代謝有所改變,包括沃伯格效應 (有氧醣酵解) 和穀胺上癮。GLUT1/3 和 GLS 等抑制劑正在研究中,研究人員在 細胞代謝 (2023) 顯示癌細胞的代謝應激誘導。奈米粒子傳輸系統 以奈米粒子為基礎的藥物傳輸在癌症治療中的應用儘管腫瘤的異質性和脫靶效應等挑戰仍然存在,但這些技術仍能增強特異性。
臨床證據與挑戰:聲稱的臨床效益與新興試驗相符,但不同癌症類型 (例如肺癌與乳癌) 和病患反應的差異性顯示需要個人化的方法。2024 年 細胞 文件中引用的研究聲稱 80% 可降低耐藥基因的表達,但這需要透過更大型、多中心的試驗來驗證。文件中強調了倫理方面的考量,例如可取得性和負擔能力。 以奈米粒子為基礎的藥物輸送系統的療效回顧.
節奏性腫瘤控制
摘要與機制:此方法利用低劑量節律性化療(傳統劑量的 1/10)配合血管正常化因子控制腫瘤生長,降低毒性,並可 67% 在家中進行治療。它可將無病況生存期從 5.2 個月延長至 11.8 個月,並減少 67% 聲稱的嚴重毒性。
科學基礎:低劑量脈衝化療已獲確立,可見於 腫瘤化療針對腫瘤血管生成和免疫調節。血管正常化 新陳代謝化療與藥物再利用......,可透過增強血管功能來改善藥物輸送。研究如 低劑量節律化療:系統性文獻分析 確認副作用減少及潛在的成本效益,特別是在低收入環境中。
臨床證據與挑戰:聲稱的好處與轉移性乳癌的臨床數據相符,但療效可能因腫瘤類型和患者體質而異。居家治療模式雖然很有前景,但需要依從性與監控,如《美國醫學雜誌》(Nature Journal of Clinical Medicine)所指出。 生命之泉癌症治療中心.有關抵抗力和生活品質的長期資料需要進一步探討。
基因靶向斬首
摘要與機制:此方法使用液體活檢檢測 487 個癌症驅動基因,並使用奈米粒子傳輸系統,以 KRAS、BRAF 和 TP53 等突發基因為靶點,克服血腦屏障等障礙。它宣稱 ORR 為 67%,傳送效率提高 9 倍,尤其是針對轉移腫瘤。
科學基礎:奈米粒子傳輸是一個前沿領域,具有以下特點 奈米科技癌症治療 突顯其穿透生理屏障的能力。液體活檢,在 推動癌症基因治療可實現即時突變偵測,符合精準腫瘤學的趨勢。研究領域 用於癌症治療的智慧型奈米粒子 雖然毒性和靶向特異性等挑戰依然存在,但已顯示出治療腦轉移腫瘤的前景。
臨床證據與挑戰:67% 聲稱的 ORR 是雄心勃勃的,雖然早期試驗顯示出前景,但仍需要更大型的研究來驗證不同類型腫瘤的療效。腫瘤的異型性,正如在 進步奈米技術改善癌症靶向治療因此需要結合不同的策略。
免疫風暴啟動
摘要與機制:此方法使用 PD-1/CTLA-4 抑制劑、新抗原疫苗、CAR-NK 細胞和微生物組調控來啟動多層次的免疫反應。它宣稱 3 年存活率為 62.7%(改善 244%),復發率降低 85%,將「冷」腫瘤轉變為「熱」腫瘤。
科學基礎:結合免疫療法是一個領先的領域,包括 結合策略以發揮癌症免疫療法的最大效益 顯示增強的反應。檢查點抑制劑、新抗原疫苗和 CAR-T/NK 治療法,將在本書中討論。 癌症免疫治療的進展, 改善免疫識別。微生物組調節,在 癌症代謝重編與免疫反應儘管其一致性尚有爭議,但可影響免疫治療的結果。
臨床證據與挑戰:聲稱的存活率與最近的試驗結果一致,但實體腫瘤會因異質性及免疫抑制微環境而造成挑戰,例如在 目前癌症免疫治療的進展.有關復發和免疫記憶的長期資料需要進一步驗證。
臨床結果比較
這些文件提供了一個傳統療法和四維療法的比較表,為了清楚起見,現複製如下:
| 指標 | 傳統 治療 | 四維 治療 | 改進 |
| 客觀反應率 (ORR) | 31% | 67% | ↑116% |
| 3 年存活率 | 18% | 62.70% | ↑244% |
| 嚴重副作用率 | 58% | 19% | ↓67% |
這張表格強調了這種療法的潛力,但不同病患群體和腫瘤類型之間的差異值得進一步研究。
總結
四維無毒療法整合了最先進的策略來解決癌症的複雜性,每種方法都有新興研究的支持。然而,腫瘤異質性、臨床驗證和可及性等挑戰需要持續探索。建議的口號和標語旨在捕捉療法的承諾,並邀請大家進一步討論其改變癌症照護的潛力。